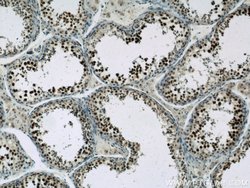
SAFB Rabbit anti-Human, Polyclonal, Proteintech:Antibodies:Primary Antibodies

missing translation for 'onlineSavingsMsg'
Learn More
Learn More
SAFB Rabbit anti-Human, Polyclonal, Proteintech
Rabbit Polyclonal Antibody
£135.00 - £349.00
Specifications
| Antigen | SAFB |
|---|---|
| Concentration | 0.17 mg/mL |
| Applications | Immunohistochemistry (Paraffin), Western Blot, Immunocytochemistry, Immunofluorescence |
| Classification | Polyclonal |
| Conjugate | Unconjugated |
| Product Code | Brand | Quantity | Price | Quantity & Availability | |||||
|---|---|---|---|---|---|---|---|---|---|
| Product Code | Brand | Quantity | Price | Quantity & Availability | |||||
|
16811415
|
Proteintech
21857-1-AP-20UL |
20 μL |
£135.00
20µL |
Please sign in to purchase this item. Need a web account? Register with us today! | |||||
|
16801415
|
Proteintech
21857-1-AP-150UL |
150 μL |
£349.00
150µL |
Please sign in to purchase this item. Need a web account? Register with us today! | |||||
Description
This antibody specifically reacts with the isoform 1 of human SAFB protein. SF3A1, also known as SF3a120, is a 793 amino acid protein, which is a Subunit of the splicing factor SF3A required for 'A' complex assembly formed by the stable bindin
This gene encodes a DNA-binding protein which has high specificity for scaffold or matrix attachment region DNA elements (S/MAR DNA). This protein is thought to be involved in attaching the base of chromatin loops to the nuclear matrix but there is conflicting evidence as to whether this protein is a component of chromatin or a nuclear matrix protein. Scaffold attachment factors are a specific subset of nuclear matrix proteins (NMP) that specifically bind to S/MAR. The encoded protein is thought to serve as a molecular base to assemble a ′transcriptosome complex′ in the vicinity of actively transcribed genes. It is involved in the regulation of heat shock protein 27 transcription, can act as an estrogen receptor co-repressor and is a candidate for breast tumorigenesis. This gene is arranged head-to-head with a similar gene whose product has the same functions. Multiple transcript variants encoding different isoforms have been found for this gene.Specifications
| SAFB | |
| Immunohistochemistry (Paraffin), Western Blot, Immunocytochemistry, Immunofluorescence | |
| Unconjugated | |
| Rabbit | |
| Human | |
| Q15424 | |
| 6294 | |
| SAFB Fusion Protein Ag16451 | |
| Primary | |
| -20°C | |
| SAFB |
| 0.17 mg/mL | |
| Polyclonal | |
| Liquid | |
| RUO | |
| PBS with 50% glycerol and 0.02% sodium azide; pH 7.3 | |
| HAP, HET, HSP27 ERE TATA binding protein, SAF B, SAF B1, SAFB, SAFB1, scaffold attachment factor B, Scaffold attachment factor B1 | |
| SAFB | |
| IgG | |
| Antigen Affinity Chromatography | |
| Antibody |
Spot an opportunity for improvement?Share a Content Correction
Product Content Correction
Your input is important to us. Please complete this form to provide feedback related to the content on this product.
Product Title